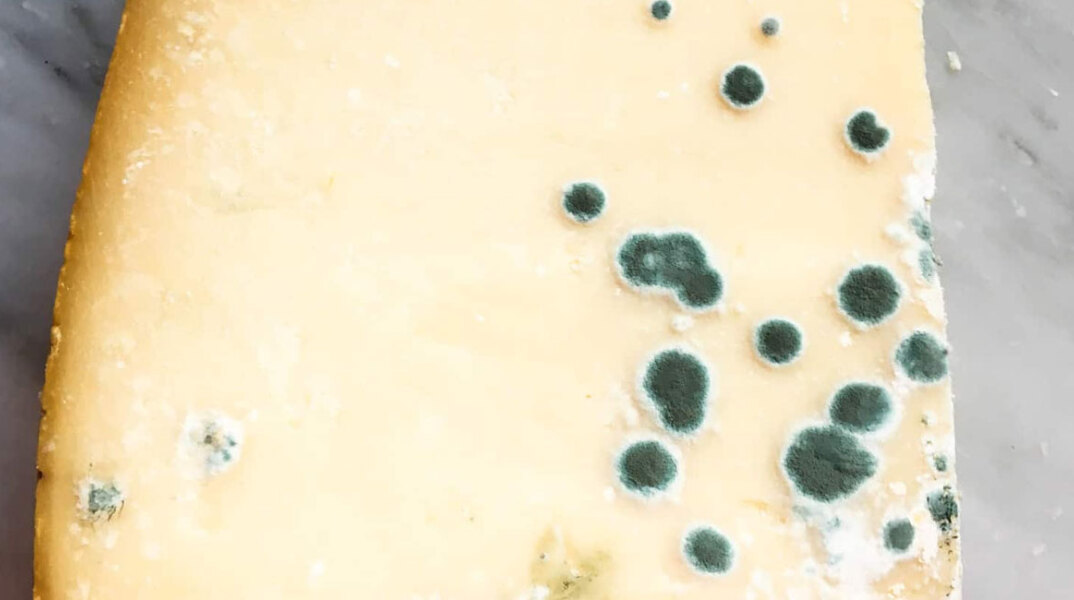
cheese-mold.jpg

- CITY GUIDE
- PODCAST
-
 17°
17°

Στην κατάσχεση 160 κιλών σκληρών τυριών, ακατάλληλων για κατανάλωση προέλευσης Ιταλίας, προχώρησαν οι ελεγκτές τροφίμων του Τμήματος Κτηνιατρικής Δημόσιας Υγείας της Διεύθυνσης Αγροτικής Οικονομίας και Κτηνιατρικής της Περιφερειακής Ενότητας Πειραιά.
Συγκεκριμένα, κατά τον υγειονομικό κτηνιατρικό έλεγχο σε επιχείρηση εμπορίου τροφίμων του Πειραιά, οι ελεγκτές κτηνίατροι εντόπισαν και κατάσχεσαν 160 κιλά σκληρά τυριά σε συσκευασίες vacuum, προέλευσης Ιταλίας.
Παρατηρήθηκαν εκτεταμένες ευρωτιάσεις (σ.σ. μούχλα) και απουσίαζε η σήμανση καταλληλότητας στις συσκευασίες των προϊόντων.
ΠΡΟΣΦΑΤΑ
ΤΑ ΠΙΟ ΔΗΜΟΦΙΛΗ

ΔΙΑΒΑΖΟΝΤΑΙ ΠΑΝΤΑ
ΔΕΙΤΕ ΕΠΙΣΗΣ
Προσωρινός αποκλεισμός της δεξιάς λωρίδας κυκλοφορίας και της Λωρίδας Έκτακτης Ανάγκης
Ο άτυχος άνδρας εργάζεται σε κρεοπωλείο
Σήμερα οι υποψήφιοι των ΕΠΑΛ εξετάστηκαν στα πρώτα μαθήματα ειδικότητας
Η ανακοίνωση του υπουργείου Παιδείας
Αναζητούνται οι μελισσοκόμοι
Ένα από τα σημαντικότερα έργα αστικής ανάπλασης της συμπρωτεύουσας
Έξι δεκαετίες μεταρρυθμίσεων, κοινωνικής αμφιθυμίας και ένα νέο ερώτημα που θέτει η τεχνητή νοημοσύνη
Σύσσωμος ο πολιτικός και δημοσιογραφικός κόσμος στον Ιερό Ναό
Τελικά μπορείς να στήνεις σκηνή όπου θέλεις το καλοκαίρι;
Ιστορική στιγμή για τον ελληνικό στρατό και τις Ένοπλες Δυνάμεις
Τι έπεσε σήμερα στους υποψηφίους των ΕΠΑΛ - Οι απαντήσεις της ΟΕΦΕ
Όπως είχε υποστηρίξει, τα χρήματα στους λογαριασμούς του προέρχονταν αποκλειστικά από τη νόμιμη αγροτική
Το χρονικό της υπόθεσης
Τι αναφέρουν οι πρώτες πληροφορίες
Σε ποιες περιοχές αναμένονται τοπικές μπόρες
Πότε θα παρουσιαστεί εκ νέου ενώπιον του ανακριτή
Έχετε δει 20 από 200 άρθρα.





















































